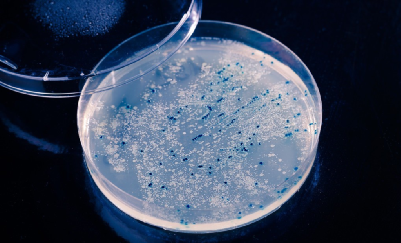

该文章转自: 鼎唐智酿学苑
葡萄酒的酿造过程与微生物密切相关,可启动酒精发酵与苹果酸-乳酸发酵,赋予葡萄酒质量与风格。而在陈酿、储存与运输时,残留在酒中的微生物可能成为降低酒质量的罪魁祸首,如不加以控制,甚至会使酒完全败坏。
微生物病害的主要种类有哪些?
霉菌病害
霉菌为好氧菌,可产生毒素污染酒体,严重危害人体健康。通常在葡萄酒与氧气接触面形成菌膜,暴露在空气中的管道接口和阀门也易受到污染

酵母菌病害
膜醭酵母俗称酒花菌,当葡萄酒感染这种菌后,会在酒的表面产生一层灰白色或暗黄色的膜,开始时呈光滑状且轻而薄,随后逐渐增厚,最终将酒液面全部覆盖,俗称酒花病。该菌会引起葡萄酒中乙醇和有机酸的氧化,使酒味变淡,并产生令人不快的怪味和过氧化味。在低酒精度葡萄酒中,产膜酵母最容易繁殖,但酒精含量较高时,繁殖会受到抑制。

醋酸菌病害
醋酸菌可使葡萄酒变酸,是葡萄酒酿造与陈酿中的大敌。这种菌在酒液表面形成一层淡灰色薄膜,最初是透明的,后来色泽变暗,有时变成一种玫瑰色薄膜,并出现皱纹,此后薄膜部分脱离,沉入桶底,形成一种粘性物体,俗称“醋蛾"或“醋母"。醋酸菌可将酒精氧化为醋酸和乙醛,然后形成乙酸乙酯。若任其发展下去,醋酸菌能将酒精全部氧化为醋酸,产生令人难以忍受的酸涩味和刺激感。

乳酸菌病害
乳酸菌就像一把双刃剑,一方面可进行苹果酸-乳酸发酵,另一方面又可引起厌气性病害。这主要取决于糖含量和酒液pH值两个因素,pH值不仅决定活动的微生物种类,还决定被分解的物质。细菌分解糖还是有机酸取决于其pH临界值,如果某细菌分解糖和分解酸的pH临界值不同,在某pH值条件下,它只能分解一种物质,这种细菌被称为纯发酵细菌。反之,如果pH临界值相近,细菌会在给定pH值条件下分解多种物质,既分解糖又分解酸,这种细菌称为异发酵细菌。乳酸菌病害常由异型发酵乳酸杆菌引起。这些乳酸菌分解葡萄酒中的酒石酸、甘油、糖等成分,引起酒石酸发酵病、苦味病、乳酸病、甘露糖醇病等,从而引起葡萄酒的败坏。

葡萄酒微生物病害的防治
葡萄酒微生物病害,如果在病原菌出现后再去控制和消除,葡萄酒的风味已经大受影响。因此,葡萄酒微生物病害的防治应以预防为主:抑制病原菌,并在可能的范围内控制发病条件。
一、预防措施

微生物病害的产生主要是由病原菌引起的。实现病原菌的控制应做到减少其数量,抑制其活性。主要应做到以下方面:
保证整个酿造环境干净卫生
保证原料质量,除去发生霉变的材料
陈酿期间,合理进行转罐,保持一定二氧化硫浓度
确保酒精发酵与苹果酸-乳酸发酵顺利进行,若出现意外,发酵过程停止,则易受其他病原菌的感染
发酵完成后,除去其中全部的微生物
依据微生物稳定性进行人工澄清
若微生物稳定性十分差,那么应该在首次转罐结束后进行过滤、离心或下胶,将酒液中的病原菌除去,或者采取巴氏灭菌法
二、发酵条件控制

病害的产生需要具备一定的条件,因此需要对发病条件进行控制,具体应做到:
应使葡萄酒充满容器并密封储存,并经常添罐(桶)。
合理选择发酵以及存储时的温度,春季环境温度会逐渐升高,应注意保持其微生物稳定性。
葡萄酒的组成与微生物病害的产生联系密切,若葡萄酒中糖分与酒精含量高,且pH值高,那么易发微生物病害。为此,应利用二氧化碳或者酒精封罐口存储,取用时将其中的二氧化碳或者酒精除去;若葡萄酒中有剩余的糖分,则应结合二氧化硫与山梨酸使用。
微生物检测
利用微生物检测与微生物计数来预测病害是否发生以及发生的程度,可以有效控制病害微生物入侵。

微生物检测和计数时要保证实验结果是由酒样中既存的微生物引起的,而不是由于环境、器皿等中的微生物的污染所造成。所以,所用到的取样容器等要保持无菌,温箱培养也应在无菌的环境下进行。这就对取样和检测过程提出了严格的要求。
